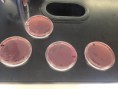
/album/fotogaleria/a13-jpg1/

¿Qué hay en los tacos de canasta callejeros?
21.05.2015 01:18
Es aún bastante temprano. Los rayos del sol han comenzado a despuntar mágicamente en el alba. Destellos que nos dan la calurosa bienvenida a un nuevo día en este gran monstruo llamado Distrito Federal. Son miles, millones de mexicanos que han salido de sus hogares para iniciar una nueva jornada, repleta de obligaciones, llena de responsabilidades que nos roban, muchas veces, nuestras mejores horas de sueño.
Para muchos ya es tarde. Gestos, miradas, movimientos. Todo refleja un sentimiento de preocupación, de temor en los angustiados rostros. Repentinamente, un olor se apodera de cada una de sus narices, entregándose por unos instantes al misterioso deleite. Un aroma con sabor a las calles del Distrito Federal que los atrapa. Cierto, el tiempo no perdona. Pero el hambre tampoco.
“Le encargo otros dos de chicharrón” dice un señor que está junto a una señora y su pequeño hijo de cuarto de primaria, que degustan con alegría, unos tacos de papa con frijol. Una señora, que se antoja una abuelita dulce y cariñosa por sus hebras de plata, le entrega cuidadosamente los alimentos al señor.
Esta linda viejecilla y su inseparable compañero, un carrito ambulante de tacos de canasta, son los encargados (como muchos) de alimentar a cientos, tal vez miles de mexicanos que, por una u otra razón, no comen en sus hogares.
Corazones y barrigas contentas que están listas para seguir con sus actividades del día. Sin embargo, bajo ese delicioso taco de chicarrón, existe una serie de peligros y amenazas que probablemente podrían o están afectando ya a miles de capitalinos y habitantes del área metropolitana.
Habitantes de un mundo que no vemos, y sin embargo, sabemos que existe. Seres que invaden nuestro cuerpo sin percatarnos de ello, gracias a esta clase de alimentos. Habitantes de un mundo microscópico, conocidos como bacterias.
En la Ciudad de México y en el área metropolitana, miles de sus habitantes ingieren diariamente alimentos provenientes de puestos ambulantes y callejeros. Ya que son una de las opciones más recurrentes a la hora del desayuno, debido a su fácil manejo, cómoda presentación y bajo precio. Por lo que son considerados una de las fuentes principales de alimentación en México.
Los tacos no se preparan al momento, son elaborados y debidamente envueltos en tela corriente, desde la casa del fabricante hasta la boca ávida del consumidor. Los más consumidos son los de mole verde de pipián, carne de res, frijoles refritos y chicharrón en salsa verde. Aunque este último es uno de los más peligrosos debido a su modo de cocción.
Con el objeto de ver cuál es la clase de componentes con las que están hechas esta clase de alimentos y las posibles bacterias que pueden llegar a albergar, se analizó en un laboratorio universitario, muestras conformadas por tacos de canasta, de chicharrón (por su peculiar preparación) obtenidos de puestos y carritos ambulantes.
Procedimiento.
El procedimiento para analizar la muestra, consistió en lo siguiente:
1.- Se esterilizan y desinfectan las pinzas con un líquido especial y el mechero bunsen (previamente encendido) para evitar que las muestras se contaminen con otras bacterias que puedan estar presentes.
2.- Se extrae cuidadosamente, una pequeña muestra del alimento en cuestión (taco de canasta) para colocarlo en un tubo de ensayo.
3.- La muestra es colocada en el tubo de ensayo junto con un caldo llamado Soya Tripticaseína, el cual posee una gran cantidad de nutrientes y propicia la proliferación y el cultivo de bacterias.
4.- La muestra dentro el tubo de ensayo, se coloca en un aparato llamado Agitador Vórtex o mezclador tipo vórtice, con el objeto de dispersar las posibles bacterias que pueden estar atrapadas en una parte de la muestra. Una vez homogeneizada, hay mayor probabilidad que se dé el crecimiento de bacterias.
5.- La muestra es incubada a 37 grados centígrados por 24 horas dentro de un contenedor especial.
6.- Después de las 24 horas, la muestras son extraídas y colocadas con un asa de inoculación (especie de pinza) previamente esterilizada, dentro de una cápsula Petri (recipiente) para asilar, dispersar e identificar las bacterias.
7.- Con la misma asa de inoculación ya esterilizada, colocar las muestras en el portaobjetos para después colocarla en el microscopio.
8.- Se hace una prueba de oxidasa. Si al colocar una muestra del recipiente Petri en la prueba, ésta se tiñe de color morado, significa que hay presencia de Enterobacterias (asociadas a enfermedades gastrointestinales) en la muestra.
9.- La muestra colocada en el portaobjetos se tiñe con un colorante especial para determinar si pertenecen a dos categorías en específico: Gram positivas y Gram negativas.
Resultados.
Los resultados de las muestras arrojaron la existencia del E. Coli que es una bacteria Coliforme con flagelos, de la familia de las entero bacterias. Existen diferentes tipos, como la EHEC (E. coli enterohemorrágica), la ETEC (E. Coli enterotoxigénica) y la EIEC (E. Coli enteroivasiva). La mayoría de las especies de este tipo son parte de la flora normal del intestino y ayudan a sintetizar vitaminas como la B y la K; sin embargo, la EPEC y la EIEC, son las que causan más infecciones.
Principalmente, se encuentran en agua contaminada y su transmisión es de carácter oral-fecal; lo que corresponde a alimentos contaminados por la falta de higiene de quienes los preparan.
Como consecuencia, se lucha con distintas afecciones en la salud, especialmente con diarreas, como la disentiría, que es un tipo que contiene sangre y restos de comida, y la “del viajero”; además de infecciones en las vías urinarias y estados sépticos, como el Síndrome de Respuesta Inflamatoria Sistémica o SIRSS.
Tratamiento.
Como tal no existe una cura específica, el tratamiento consiste en el suministro de antibiótico utilizados. En casos de mayor riesgo, el tratamiento tiene como objeto controlar los síntomas de la infección, por lo cual, se recurre al uso de terapias como la rehidratación para la diarrea y la diálisis para contra restar el daño renal.
La mayoría de los infectados E. Coli, se recuperan automáticamente tras un proceso una semana a diez días.
Las medidas que se deben tomar para prevenir el contagio por esta bacteria son:
• No ingerir lácteos y alimentos no pasteurizados.
• Lavarse las manos después de utilizar el baño.
• Cocinar la carne a una temperatura mayor a 70º C.
• Conservar la carne cruda separada de otros alimentos, y tener una correcta higiene de las superficies y utensilios de cocina después de haber tenido contacto con carne o verduras.
• Beber agua purificada, de preferencia agua embotellada, incluso para lavarse los dientes.
• Lavar con agua y jabón las verduras crudas.
Con estas medidas, la presencia de E. Coli en el organismo y sobre todo la difusión de la misma, será muy limitada y por lo consiguiente se evitarán los daños críticos a la saluda que dicha bacteria conlleva.
Ciertamente, cuando se nos habla de peligro, usualmente nos ponemos a pensar en términos o definiciones de inseguridad, corrupción, narcotráfico entre otras cosas. Se nos olvida a veces que también existen otras clases de peligro. Uno de ellos es invisible para nuestra vista, pero tan dañino como los mencionados. Uno que se presenta no como arma de fuego, ni en forma de drogas, sino como un delicioso alimento, al cual no tememos. Al contrario, lo aceptamos y saboreamos con gusto. Ya lo sabes, la próxima vez que te encuentres frente a un puesto de tacos o hamburguesas en la gran ciudad, piénsalo dos veces antes de ingerir alimentos en estos puestos callejeros. Ya saben lo que dicen de la comida mexicana: deliciosa pero letal.